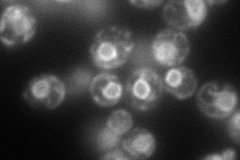
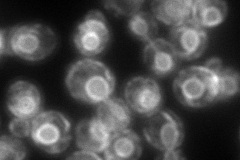
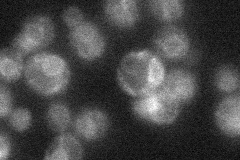
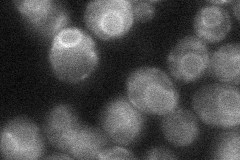
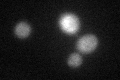
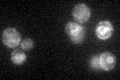

View description
Alpha-1,6-mannosyltransferase localized to the ER; responsible for the addition of the alpha-1,6 mannose to dolichol-linked Man7GlcNAc2, acts in the dolichol pathway for N-glycosylation
Localization:
Intensity:
Fold change:
Significance:
-
C’ GFP library in SD

ER34.1 -
N' NOP1pr-GFP in SD
ER144.225 -
N' TEF2pr-mCherry in SD
ER150.872 -
N' NATIVEpr-GFP in SD
ER22.8209 -
N' TEF2pr-VC and Cyto-VN in SD
ER39.5197 -
C’ GFP library in SD+DTT
ER24.450.71No -
C’ GFP library in SD+H2O2

ER28.30.82No -
C’ GFP library in Starvation Media
ER44.391.3No -
C’ GFP library on the background of Pup2-DaMP

ER -
C’ GFP library on the background of CCT mutant

ER28.49430.835357No
